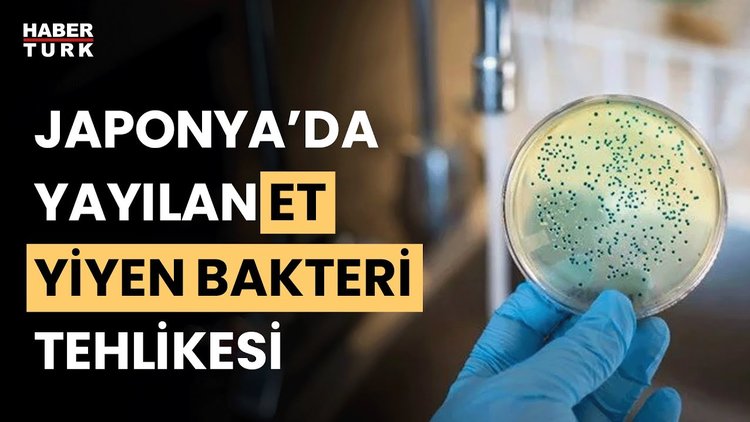
Japonya&#039;da &quot;et yiyen&quot; bakteri vaka sayısında rekor! Uzmanlar neden çağrıda bulundu?

Japonya'da sel felaketi: En az 38 ölü, 50 kayıp
7 Temmuz 2018 - 17:27
Japonya, bugünlerde tarihinin en şiddetli sel felaketiyle karşı karşıya... Takahashi kentinde etkili olan şiddetli yağışlar sel ve su baskınlarına yol açtı. Caddeler nehre döndü; evleri su bastı. Binalarda ciddi hasarlar oluştu. Sadece maddi hasar değil, çok sayıda can kaybı da var. En az 38 kişinin hayatını kaybettiği felakette, 50 kişi ise kayıp...
Özellikle ülkenin batısında ve merkezinde 1 milyon 600 bin kişi evlerini terk etmek zorunda kaldı. Binlerce kişi ise evlerinde mahsur... Kurtarma ekipleri alarma geçti; mahsur kalanlar helikopterle tek tek kurtarıldı.
Yağışların devam edeceği uyarısında bulunan Japonya Meteoroloji Ajansı, halkı tahliye emirlerine uymaya çağırdı. Japonya ordusunun da tahliyelere destek verdiği bildirildi. Halktan mecbur kalmadıkça dışarı çıkmamaları istendi.